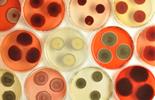

你應該要知道的食事
台灣座落於太平洋之上,是四面環海,海洋資源豐沛的海島國家,但在這樣海洋資源豐碩下的島國台灣,卻讓海鮮混充的問題不斷發生,這一切都是源自於我們對於食魚教育的匱乏,從魚種到漁法,為了達到良好的循環,從漁民、漁會到消費者應該要達到善的循環,才能杜絕海鮮混充的亂象。
採訪・撰文=李依文
不管是在吃海鮮,或是購買海鮮的時候,你可曾想過這些海鮮來自哪裡?是來自養殖或是捕撈?這些問題可能不曾出現在你的腦海中,除了是因為台灣的食魚教育不夠落實之外,同時伴隨而來的問題就是海鮮混充的亂象。
從海洋到餐桌,環環相扣,究竟是哪個環節出錯了,讓這樣的問題無法被徹底根絕?
混充亂象一:產地海域不明,讓不肖業者容易賺取價差
在台灣,海鮮的取得相當容易,來源相當的廣泛,不管是海撈還是養殖或者進口,同一種魚的來源可能會有相當多種。
台灣目前在海鮮的產地溯源上,即使有相關法規的規範,但來源地的正確性仍舊是具備挑戰性的,僅標示來源國家是不夠的。
不同海域有不同的生長環境條件,讓同樣的魚種會因著不同的海域環境條件,而有不同的口感與風味,所以不同海域造就的品質差異,連帶影響價格。也因此,不肖業者就可能藉由所謂「洗產地」從中獲取更大的利益。
舉例來說,同樣都是來自台灣,有澎湖「白金」之稱的土魠,每年農曆春節前夕洄游至澎湖海域,也是土魠油脂最肥美的季節,全是為求累積足夠的能量準備產卵。但澎湖這樣得天獨厚的海域環境,本島的環境卻沒辦法賦予土魠這種生長條件,所以本島附近捕撈上岸的土魠肉質也就沒這麼鮮美。台灣永續鱻漁協會理事長白尚儒透露,造就了本島所產的土魠就曾發生在澎湖轉手,再賣回台灣本島,價格可以達到5倍的差價。因此產地溯源究竟應該怎麼做才能有效管理,成為了一個必須解決的議題。
混充亂象二:重量標示不明,包冰率沒有強制規範
許多消費者購買冷凍海鮮回家後,打開包裝,明明包裝沒有破,為什麼會有一大堆水在裡面,取出的海鮮更是比原本預想的量少非常多,難道是被騙了嗎?又或是滿心期待地把冷凍海鮮流水退冰,等到待料理的時候,卻發現退冰海鮮縮水了!心中常會浮現一個疑問,所花的錢究竟是買海鮮,還是買到冰塊?
以現行的法規來說,未硬性規定標示「包冰率」的標示,導致於不肖廠商會增加包冰的含量,以獲得更高的利潤,也引發消費爭議。
海鮮以-18℃冷凍過後,浸漬於0-2℃的水中5秒左右,海鮮的表面會形成一層薄薄的冰衣,這個動作即稱之為「包冰」。而「包冰率」即是指冰衣的重量與海鮮的重量比,一般會用百分比來表示,同樣的包冰動作反覆浸漬,就可以將冰衣加厚,包冰率也就會隨之提升。
混充亂象三:管理權責未落實,改標再售、產地混充難以杜絕
保存期限竄改,是台灣常見的海鮮混充現象之一,相較之下,以品項同樣豐富的農產品來說,農產品所能做到的溯源管理在近年來已有很大的進步。
同樣在台灣,農產品的追蹤追溯、批號管理、有效日期等,甚至是做出在地品牌,除了政府投入資源推廣、產業也持續朝透明化方向邁進,最終目標除了可提升消費者信任感外,農民也可以自身所出產的產品感到驕傲,假若農產品能做到這種程度,身為島國的台灣,為何水產品不能做到這種程度?而同樣是島國的鄰國日本,又是怎麼管理的呢?
日本水產廳,相當於台灣的漁業署,將管理職權直接交給在地漁會,在地漁會可以對在地漁民進行管理與約束,漁民需要實名登記、漁船及漁獲量、甚至是交易量、交易單據等均須申報相關紀錄。且為了防止非法捕撈進而減少國內漁業資源,日本所有的漁業交易都需要建立紀錄,交易單據與紀錄均須妥善保存,最終目的是為了促進漁業和相關產業有良好的發展空間。
但在台灣,漁會較難以實質管理。「漁會是漁業署與漁民之間溝通的管道。」行政院農委會漁業署副署長林國平說,在地漁會屬於一個獨立的機構,當漁業署需要執行新的政策時,會委託漁會擔任宣導的角色,與漁民溝通,漁民若有需求也能透過漁會來傳遞訊息。
基隆市產業發展處海洋與農漁發展科科長蔡馥嚀與《食力》說明,在地漁會主要的管轄範圍在港區內,內容與地磅、衛生環境等有關,對於漁民並沒有管理的義務與權限,許多地方上漁法、食魚教育的推動還是要依靠地方政府來推行。
此外,蔡馥嚀也說明,「台灣的漁船管制方法,是根據漁船的公噸數大小來分管理單位,以CT3(20噸以上未滿50噸)為界線,超過此級距的隸屬於漁業署管理,以下的由地方政府管理。」
綜上所述,目前台灣漁業管理方式,無論是中央地方、政府民間之間的串連都不夠,都無法直接管理漁民、也還無法全面確保漁獲的來源與流向,暫時難以解決台灣現在消費市場所碰到的混充現象。
而在這些的亂象之下所伴隨的不僅是存在利益層面而已,背後更是埋藏著食品安全的檢驗漏洞。
海鮮混充亂象隱藏食安漏洞
海鮮混充為何會造成食品安全疑慮,問題全出在魚種或是漁貨來源標示的不明確,在現行的檢驗機制上就會產生漏洞,進而成為無人知曉的食品安全問題。
主要是因為每一種魚種,甚至是生長的海域不同,都會有各自需要特別注意的檢驗安全項目,以台灣的檢驗現況來說,檢驗公司在接受委託檢驗案件時,只會根據客戶提供的申請需求來做檢驗,這樣的情況之下若是碰到上游混充供貨的海鮮,下游的廠商若無法辨別,且想要依循規矩去做檢驗,就會碰到拿甲魚去驗乙魚的狀況,不僅是送檢人不知道自己造成烏龍一場外,無形中也變成一種安全漏洞。
海鮮混充亂象,漁民、政府、消費者都該負責
以台灣的現況來說,有多方的亂象根源環環相扣,導致台灣現今的海鮮混充問題層出不窮。
以漁業管理機制來說,台灣的漁會有會員機制可以自行申請加入,但加入漁會對於漁民來說,並沒有太大的實質幫助,導致漁民或魚販也可不選擇加入會員而自行販售自己的漁獲。與日本相比,台灣在地漁會沒有管理義務,漁民在販售漁獲時就缺少了系統性的管理規範。
再者,消費者在購買水產品時,有時候更重視水產品的價格而非品質,且對於漁獲的不了解、無法自我把關等,通路對於進貨的魚種、產地等也少有反向的追溯與確認,種種的因素綜合下來,讓台灣的海鮮冒充事件無法杜絕。
食魚文化的推廣應加速 才能從消費端反制海鮮混充亂象
綜合種種,為何海鮮混充狀況頻生,終歸於我們身處海島,身為海島人,擁有豐沛的海洋資源,卻不理解海洋,導致了這樣的惡性循環產生,在地漁業文化非常豐富的資源下,在地人應該要有責任認識在地的漁業資源等,而不是因為不了解,造成諸多的紛爭發生。這也是「食魚教育」的重要性,當我們都全然了解全貌後,從了解到監督,也能降低海鮮混充發生的可能性。政府、漁民、消費者三方應該要建立出良好的循環,台灣的海鮮文化才能存在更好的永續發展空間。
因此,《食力》本次專題就帶大家來了解,從海洋到餐桌會造成所謂「海鮮混充」的三大原因為何、又會衍生出哪些問題?另外提供辨識鮮魚的方法,讓消費者在選購的時候,先了解魚,再吃好魚。
審稿編輯:童儀展、林玉婷
延伸閱讀
▶【產地海域不明】混產地賺取價差亂象多!該如何強化產地標示規範?!
▶【重量標示不明】買水產好像買冰磚?「包冰率」未標明惹爭議
▶【管理權未落實】為什麼海鮮標示那麼亂?竄改保存期限、海域不明都是灰色地帶!